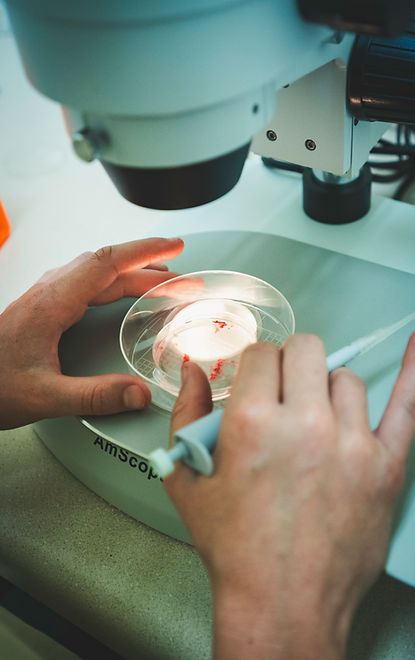
DSC00482.jpg

FAQs
Frequently Asked Questions
We understand that the decision to use beef cattle embryo transfer and in vitro fertilization through individually tailored solutions is a significant one. Learn more about the processes and other frequently asked questions. If you still have more questions, we would love to hear from you. Reach out through our contact page.
General Embryo Transfer Questions
What makes a good donor?
At its core, a good donor cow is simply a good cow. But what defines a good cow? She is one that breeds easily, calves without difficulty, raises a healthy calf, and is able to breed back within 45–60 days.
For this level of productivity, assuming proper management is in place, the donor must meet certain biological requirements. Chief among these are mature ovaries that are both adequately sized and active.
At Dogwood Genetics, one of the keys to our success is the consistent use of ultrasound technology in donor management and evaluation. Ultrasound allows us to assess ovarian activity, evaluate embryo production potential, and tailor our protocols to maximize each donor’s productivity.
How do I manage my donors and recipients?
At Dogwood Genetics we find that successful donor and recipient management starts with keeping both groups in prime health. Donors should be on a consistent nutrition and mineral program, properly vaccinated, and monitored closely for reproductive soundness to maximize embryo quality. Recipient cows require the same level of care, with added emphasis on synchronization protocols, body condition, and overall wellbeing to ensure higher conception rates. Our team works with producers to track health, nutrition, and reproductive status so that donors, recipients, and clients are set for long-term success.
Embryo Retrieval Questions
What is embryo transfer?
Embryo Transfer is a topic that is vast in its own right, but at its core, it is a way to multiply the genetics of your best cows. Through this process, embryos are generated from a donor female, and transferred to a recipient cow who carries the pregnancy. This allows producers to make faster genetic progress, increase the number of calves from elite females, and maximize the value of their herd’s genetics at a much faster rate. ET has done for the female what AI did for the male, multiplying her genetic impact on the herd rapidly.
What is conventional flushing (MOET)?
In MOET, donor cows are superovulated and the donor is bred. Seven days later embryos are collected and frozen for storage, or transferred fresh to recipients. This process allows producers to multiply the genetics of their top females, while keeping donors in a program that prioritizes their health and productivity. Each donor is an individual and we customize her superovulation protocol to maximize her potential as an embryo producer. Embryos generated via MOET tend to have higher conception rates and lower rates of embryonic mortality compared to their IVF counterparts. ​Donor housing is available.
What is in vitro fertilization?
In vitro fertilization (IVF) is an advanced reproductive technology that allows embryos to be created outside the cow’s body (in vitro). Oocytes are collected directly from the ovaries of a donor cow, matured and fertilized with semen in the laboratory, and then cultured for seven days. The resulting embryos are either transferred into synchronized recipient cows or frozen for future use.
​
Many producers are choosing IVF because of the flexibility it offers. Aspirations can be performed every two weeks, compared to the 5–7 week interval required with conventional embryo transfer. Pregnant females can also be aspirated early in gestation, before the pregnancy becomes too advanced. Donors that do not respond well to hormone treatments used in traditional flushing often perform more successfully with IVF.
​
Perhaps the greatest advantage of IVF is its ability to extend the reproductive longevity of the donor cow. By using minimal hormone supplementation and reducing stress, donors are able to maintain efficiency and productivity. This approach allows producers to fully capture the genetic potential of elite cows without compromising their long-term health. ​Donor housing is available.
CURRENT IVF SCHEDULE
Dogwood Genetics is a PWP with TransOva Genetics working with the Lawrenceville lab. We do IVF every Tuesday (excluding major holidays). The current schedule is: ​
-
June 2
-
June 9
-
June 16
-
June 23
-
June 30
-
July 7
-
July 14
-
July 21
-
July 28
-
August 4
-
August 11
-
August 18
-
August 25
-
September 1
-
September 8
-
September 15
-
September 22
-
September 29
​
What is the difference between conventional flushing and in vitro fertilization?
Conventional flushing and IVF are both tools that are utilized here at Dogwood to multiply genetics, however, they differ in how embryos are created. In a conventional flush, the donor is bred multiple times after following a tailored hormone schedule, and embryos are collected about a week later. IVF involves collecting unfertilized eggs (oocytes) directly from the donor's ovaries and fertilizing them in the lab, hence, in vitro fertilization.
​
Conventional flushing often produces a strong number of transferable embryos, but it relies on the donor cycling normally and requires more hormonal usage. IVF, on the other hand, typically uses fewer hormones and allows for more flexibility - including the ability to use less semen, reverse sort semen for male or female calves, and work with donors that are younger, older, or not cycling adequately.
​
We respect that every operation is different, and our client base is vast, with each producer choosing the approach that best fits their herd goals and management style. Many find value in using both technologies strategically depending on their donors, their scheduling, and their preferences.
How many viable embryos should I expect from a conventional flush?
On average, a conventional flush will yield 6-10 viable embryos on a mature donor, though results can vary widely. Some flushes may produce over a dozen transferable embryos, while others may result in only a few. The differences are influenced by several factors, including the donor’s age, fertility, nutrition, body condition, and overall health. Management practices such as synchronization, hormone response, and timing also play a key role, as well as the skill of the team performing the collection. At Dogwood, we tailor hormone protocols to each donor, and closely monitor them through ultrasound technology to track follicular development and ensure the best timing for stimulations, breeding, collections, etc. This level of care, combined with sound management and experienced technicians, helps optimize results for each individual donor, and the success of our clients.
How many viable embryos should I expect from IVF?
With IVF, not every oocyte (egg) collected develops into a viable embryo. On average, about 30-40% of collected oocytes will mature and successfully fertilize into transferable embryos. The exact percentage depends on the donor’s fertility, age, and oocyte quality, as well as the quality of semen and laboratory conditions. At Dogwood, we monitor donors with ultrasound, manage oocyte collections with precision, and partner with advanced laboratories to maximize fertilization rates and embryo quality.
Donor Questions
How soon after calving can I flush my donor?
For conventional flushing, we typically start the set up no earlier than 45-50 days postpartum, with the actual flush occurring around 60-75 days after calving. IVF, on the other hand, can be performed no sooner than 45 days postpartum. These timelines allow donors to recover, cycle normally, and return to good body condition. At Dogwood, we evaluate each donor individually and use ultrasound technology to monitor uterine and ovarian health, ensuring collections are performed at the optimal time for both the donor and embryo quality.
How often can my donor be flushed?
The frequency a donor cow can be flushed depends on her health, physiology, and reproductive condition.
​
For conventional flushing, we typically use a 50-60 day turnaround between flushes. About 30 days post-flush we begin a 31 day setup protocol for all donors running conventionally. We generally do not recommend flushing more than 8 cycles (16 months) in a row, as prolonged hormone use can cause the donor’s ovarian lining to thicken, and days open lead to weight gain. The number of embryos recovered also provides a key indicator - if recovery rates drop, it is a sign the cow may need a break, be bred back, or otherwise regain balance.
​
IVF donors can be collected every 2 weeks for a period of 6-8+ months consecutively. Similar to conventional flushing, extended use can lead to weight gain, and declining oocyte numbers or quality signal it is time to rest her or breed her back before continuing.
​
Luckily, modern reproductive technology allows for flexibility. For example, a cow can be conventionally flushed or ran IVF, given a break, bred back, and later used for IVF until she is too far along and the ovaries cannot be picked up.
​
Every donor female is different, and her response to flushing varies widely. That is why we take extreme caution in monitoring both her health and her embryo/oocyte production, which is essential to ensure she remains productive, healthy, and ready.
Recip Questions
How many times can I reuse my recips?
We do find that the answer varies from client to client. Recipients can be reused as long as their body allows. Age, dystocia cases, reproductive history, and overall health are the main things clients should always take note of. After a successful Embryo Transfer Pregnancy, it is always important to evaluate the cow before considering another transfer. Each cow must be assessed individually to maximize your overall success.
Bear in mind embryo pregnancies are your highest valued pregnancies, therefore, careful consideration should be given to each female that is selected to receive an embryo. Problem cows who have struggled to breed in the past, or cows who consistently have poor calves, are not prime candidates for the important job of raising your next generation of CHAMPIONS.
How quickly after calving can I use a cow as a recip?
Recipient cattle can generally be used 45-60 days after calving, once their reproductive system has recovered and they have returned to normal cycling. However, it is important to note, factors such as difficult labor, a large calf, or older age can affect the females turn around rate. Ensuring the cow is in good body condition, receiving proper nutrition, and free of health issues is essential for a prosperous embryo transfer. Careful monitoring during this period helps confirm she is ready to carry an embryo and supports the best possible outcome.
What are the best ways to sync up my recips?
Synchronizing recipient cows is key to ensuring they are ready to receive embryos at the optimal time. This can be done using prostaglandin protocols, which bring cycling cows into estrus, or progesterone-based protocols, such as CIDR devices, which help regulate the estrous cycle. Many farms use combination protocols to increase precision and improve success rates. Careful monitoring - including heat detection, reproductive exams, and sometimes ultrasound evaluations - ensures each recip is at the right stage for transfer. By being dedicated to these practices, clients can maximize synchronization success and increase the likelihood of a healthy, viable pregnancy.
​
We find the seven day co-synch with CIDR to be the most cost effective way to maximize success. This is the protocol you will be sent when you get a transfer date. Using this protocol we are able to implant approximately 80% of recipients synchronized, including about 50% of those recipients who do not show heat with good success. We recognize the validity of all the protocols published by the Beef Reproductive Task Force.
​
How do I make sure my recipients are in good condition to receive an embryo?
The health and readiness of recipient cows are just as important as donor health and embryo quality. To maximize the chances of a successful pregnancy, recipients should be in good body condition, nutritionally balanced, and free of reproductive or health issues. Implementing good grazing and forage management protocols is essential to maintain consistent nutrition and overall health. Regular veterinary care, proper vaccination, and reproductive evaluations also play a key role. By carefully managing these factors, clients can help ensure their recipients are well prepared to carry embryos successfully and efficiently.
Embryo Viability and Conception Questions
My donor produced non-fertile or degenerate embryos- what happened?
Occasionally, a donor cow may produce embryos that are non-fertile or degenerative. This can happen for a variety of reasons, including the quality of oocytes, semen quality, the donor's health or stress levels, genetic factors, or conditions during the laboratory process. While these embryos cannot be transferred, we carefully evaluate the donor and her protocol to identify any adjustments that may improve future results. Our goal is always to support the health of the donor and maximize the chances of producing viable, high-quality embryos with each flush we perform.
What is the normal pregnancy rate for fresh and frozen embryos that are transferred?
Pregnancy rates vary depending on whether embryos are fresh or frozen whether they come from conventional flushing or IVF. With proper recipient management, we see fresh conventional embryos, the conception rate is typically around 70%, while fresh IVF embryos average around 60%. On some farms, these rates can reach heights of 80% for conventional and pushing 70%+ for IVF. Factors such as recip health, reproductive management, and time of year can all influence success. For frozen embryo transfers, conception rates generally drop by about 10% for both conventional and IVF embryos. By carefully monitoring both donors and recips, we strive to maximize the chance of a healthy, successful pregnancy every time, and our records prove that.